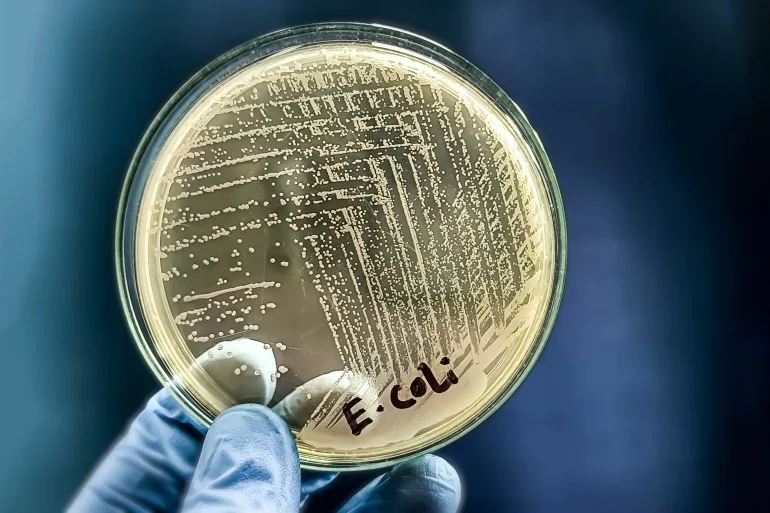

الـخـلاصـة
- 🔹 الملخص
- 🔹 تحليل
- 🔹 أسئلة شائعة
بكتيريا تدافع عن نفسها بآلية فريدة مستوحاة من بقايا فيروسات قديمة. اكتشف باحثون من جامعة بنسلفانيا كيف تستخدم البكتيريا هذه البقايا الفيروسية لإنتاج بروتينات دفاعية تحميها من الهجمات الفيروسية الجديدة. تعمل هذه الآلية عن طريق تفعيل أجزاء من الحمض النووي الفيروسي القديم، مما يؤدي إلى إعادة تشكيل مستقبلات سطح الخلية البكتيرية. هذه الآلية قد تساعد في تطوير طرق جديدة لمكافحة البكتيريا المقاومة للمضادات الحيوية، وتعزيز استخدام البكتيريا النافعة في الصناعات الغذائية.
ℹ️ خلاصة مختصرة لأهم ما جاء في الخبر قبل التفاصيل
تقول العبارة الشهيرة "الضربة التي لا تقتلني تقويني" وإذا كانت تستخدم في عالم البشر مجازيا، للدلالة على أن التحديات التي لا تؤدي إلى الهلاك تكسب الفرد قوة وصلابة، فإنها في عالم البكتريا تتجاوز الحالة المجازية، لتصف آلية واقعية وعملية، تتحول بموجبها الضربات التي كانت تستهدف قتلها إلى أدوات تكسبها مزيدا من القوة والصلابة.
ومنذ مليارات السنين، تخوض البكتيريا والفيروسات معركة مستمرة، فالفيروسات تهاجم البكتيريا باستمرار، والبكتيريا تطور أساليب للدفاع عن نفسها، وهذا الصراع الطويل أنتج آلية دفاعية مذهلة داخل البكتيريا، هي التي تعد ترجمة عملية للعبارة الشهيرة.
واكتشف فريق بحثي من جامعة بنسلفانيا الأميركية هذه الآلية، التي كانت مهملة سابقا داخل بعض سلالات بكتريا "إيكولاي" ووجدوا أن فهمها قد يساعد البشر في عده مجالات أبرزها تطوير وسائل جديدة لمحاربة البكتيريا، خاصة مع تزايد مقاومتها للمضادات الحيوية.
ما هذه الآلية؟
تبدأ قصة هذه الآلية الدفاعية بتعرض البكتيريا لهجمات متواصلة من فيروسات تُعرف بـ"العاثيات" وبعض هذه العاثيات تتبع خطة مختلفة، فهي لا تدمر الخلية فورا، بل تعيش داخلها بهدوء، انتظارا للظروف المناسبة للهجوم.
ولكن في بعض الحالات، تفقد هذه الفيروسات القدرة على الهجوم تماما وتتحول إلى ما يسميه العلماء "العاثيات الخفية" وهي بقايا فيروسية لا تموت ولا تعمل، لكنها تبقى.
والجديد الذي اكتشفه العلماء في الدراسة المنشورة في دورية "نيوكليك آسيدز ريسيرش" أنه مع مرور الزمن، توارثت الأجيال البكتيرية هذا الفيروس الصامت داخل جيناتها، دون أن يسبب أي ضرر.
ولم تترك البكتيريا هذا الإرث الفيروسي بلا فائدة، بل طورت آلية ذكية تستغل هذه البقايا لصالحها، فحين تتعرض لهجوم جديد من فيروس آخر تفعل أجزاء من الحمض النووي الفيروسي القديم، فتنتج بروتينات دفاعية تمنع الفيروس المهاجم من الالتصاق بالخلية أو اختراقها.

كيف تعمل الآلية الدفاعية؟
ويصف الباحثون في دراستهم هذه الآلية، والتي يبدأ تفعيلها عندما يقترب فيروس جديد محاولا الهبوط على سطح البكتيريا لبداية الهجوم.
فعند أول محاولة لمس تنطلق إشارة إنذار داخل الخلية، حيث يدخل إلى المشهد إنزيم يختص بإعادة التركيب "بنكيو" والذي يشبه مهندسا جينيا طارئا يتدخل للإنقاذ، حيث يبدأ تنفيذ حركة دقيقة داخل الحمض النووي للبكتيريا تسمى "الانقلاب الجيني" أي قلب جزء صغير من الشفرة الوراثية، تحديدا الجزء الذي يحتوي على آثار الفيروس القديم.
وبهذه الحركة، تُفتح صفحة جينية كانت خاملة، وتُفعل البكتيريا تعليمات جديدة لم تكن تُقرأ سابقا، والنتيجة تكون تصنيع بروتينات هجينة، تكون مزيجا من جينات البكتيريا وبقايا الجينات الفيروسية القديمة.
وتتجه هذه البروتينات الهجينة إلى سطح الخلية، وتعيد تشكيل مستقبلات البكتيريا، وهي تلك النقاط التي يعتمد عليها الفيروس المهاجم للالتصاق والحقن، وفجأة يجد الفيروس الجديد نفسه أمام سطح مجهول لا يستطيع التعرف عليه، وبالتالي لا تجد الفيروسات التي حاولت أن تهبط بابا ولا نافذة، وبالتالي يكون الدفاع قد نجح قبل أن يبدأ الهجوم.
تجربة عملية على بكتريا إيكولاي
واختبر الباحثون هذه الآلية عبر زيادة إنتاج البروتينات الهجينة في بكتيريا "إيكولاي" ثم تعريضها للفيروسات وتركها طوال الليل، وبعد ذلك قاسوا عكارة المحلول، فكلما زادت العكارة قل وجود الفيروسات، كما أجروا نمذجة حاسوبية لمحاكاة التصاق الفيروسات بالبكتيريا، وتأكدوا من صحة نتائجهم من خلال التجارب.
ويقول البروفيسور توماس وود أستاذ الهندسة الكيميائية بجامعة بنسلفانيا، والباحث الرئيسي بالدراسة -في بيان نشره الموقع الإلكتروني للجامعة- إنه عندما نزيد إنتاج البروتين الدفاعي ننجح في منع الفيروس من الالتصاق بالبكتيريا في البداية "لكن بعد 8 دورات تجريبية، ينجح الفيروس في تطوير بروتينات هبوط جديدة تمكنه من تجاوز الدفاع".
وأكد وود أن هذه النتائج تحسن فهم آليات الدفاع الطبيعية لدى البكتيريا، مما يمكن أن يُوظف مع البكتريا النافعة التي تستخدم في صناعات مثل الجبن والزبادي، وأيضا مكافحة الأنواع الممرضة المقاومة للمضادات الحيوية. وأضاف أن الفريق سيواصل دراسة 8 "عاثيات خفية" أخرى لمعرفة دورها المحتمل في الدفاع.
تحليل وتفاصيل إضافية
تكشف هذه الدراسة عن آلية دفاعية معقدة في البكتيريا، حيث تستخدم بقايا الفيروسات القديمة لصالحها. هذا الاكتشاف يوضح كيف يمكن للكائنات الحية أن تتكيف وتطور استراتيجيات مبتكرة للبقاء على قيد الحياة. الأهمية تكمن في إمكانية تطبيق هذه المعرفة في مجالات مثل الطب، حيث يمكن استخدامها لتطوير مضادات حيوية جديدة تتغلب على مقاومة البكتيريا. بالإضافة إلى ذلك، يمكن استخدام هذه الآلية لتعزيز البكتيريا النافعة المستخدمة في الصناعات الغذائية. يبقى التحدي في فهم التفاصيل الدقيقة لهذه الآلية، واستكشاف كيفية عملها في أنواع مختلفة من البكتيريا.
أسئلة شائعة حول بكتيريا تدافع عن نفسها
ما هي الآلية التي تستخدمها البكتيريا للدفاع عن نفسها؟
كيف تساعد هذه الآلية في مكافحة مقاومة المضادات الحيوية؟
ما هي ‘العاثيات الخفية’؟
ما هو دور إنزيم ‘بنكيو’ في الآلية الدفاعية؟
ما هي البروتينات الهجينة؟
ما هي تطبيقات هذه الدراسة المحتملة؟
📌 اقرأ أيضًا
- ناسا تعرض صورة جديدة لجارتنا الأقرب مجرة “المرأة المسلسلة”
- سمكة تختنق بحبار.. أول دليل أحفوري لـ”غذاء قاتل” قبل 150 مليون سنة
- بصمات “الأرض الأولى”.. الكشف عن عالم مفقود في باطن كوكبنا
- لماذا يريد العلماء نثر “هباء كيميائي” في غلاف الأرض الجوي؟
- مخططات فاينمان.. الرياضيات تحل واحدة من أشهر مشكلات الفيزياء
